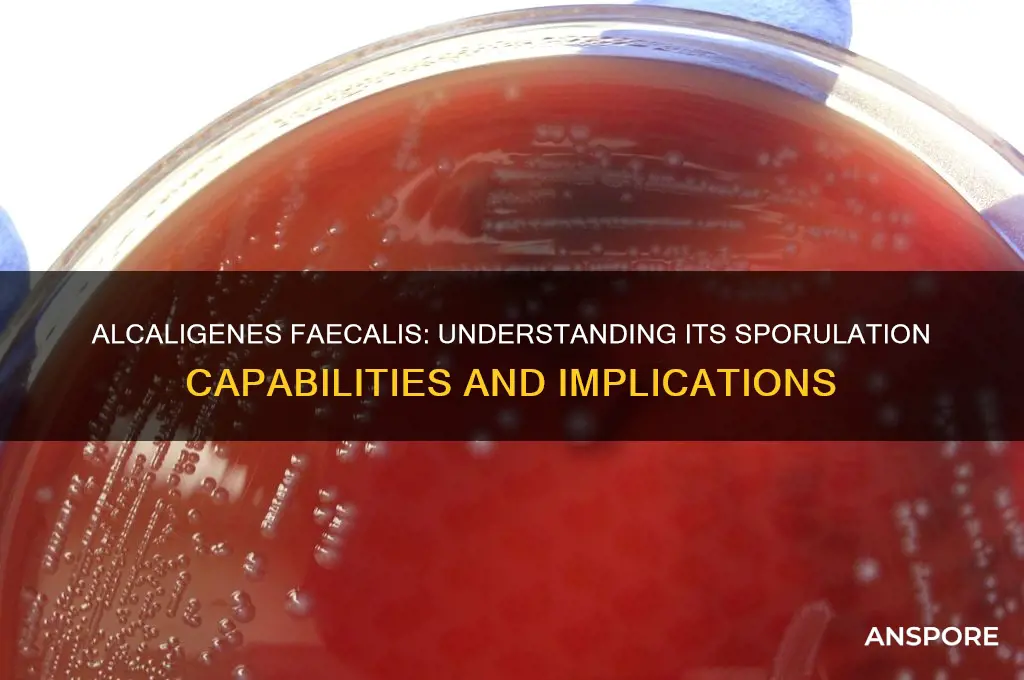
does alcaligenes faecalis form spores

*Alcaligenes faecalis*, a Gram-negative, rod-shaped bacterium commonly found in soil, water, and the gastrointestinal tracts of humans and animals, is known for its metabolic versatility and ability to degrade various organic compounds. Despite its widespread presence and ecological significance, one question that often arises is whether *Alcaligenes faecalis* forms spores as a survival mechanism. Sporulation is a characteristic feature of certain bacteria, such as *Bacillus* and *Clostridium*, which allows them to withstand harsh environmental conditions. However, *Alcaligenes faecalis* does not form spores; instead, it relies on other strategies, such as biofilm formation and metabolic adaptability, to survive in diverse and sometimes challenging environments. Understanding its lack of sporulation is crucial for assessing its role in environmental processes and its potential impact on human health and industrial applications.
| Characteristics | Values |
|---|---|
| Spore Formation | No, Alcaligenes faecalis does not form spores. |
| Gram Staining | Gram-negative |
| Morphology | Rod-shaped (bacilli) |
| Motility | Motile (with peritrichous flagella) |
| Oxygen Requirement | Facultative anaerobe |
| Optimal Growth Temperature | 25–37°C (mesophilic) |
| Optimal pH Range | 6.5–7.5 |
| Habitat | Found in soil, water, and gastrointestinal tracts of animals and humans |
| Metabolism | Heterotrophic |
| Pathogenicity | Generally considered non-pathogenic, but rare cases of infection exist |
| Antibiotic Susceptibility | Susceptible to most common antibiotics |
| Biochemical Tests | Oxidase-positive, catalase-positive, urease-negative |
| Colony Characteristics | Smooth, convex, and creamy colonies on agar plates |
| Genome | Single circular chromosome |
| Ecological Role | Involved in nutrient cycling and biodegradation in environments |
Explore related products
What You'll Learn
- Sporulation Conditions: Examines environmental factors influencing potential spore formation in *Alcaligenes faecalis*
- Morphological Evidence: Analyzes cell structure for spore-like features in *A. faecalis*
- Genetic Basis: Investigates genes related to sporulation pathways in *A. faecalis*
- Survival Mechanisms: Compares spore formation with other *A. faecalis* survival strategies
- Experimental Studies: Reviews research confirming or denying spore formation in *A. faecalis*

Sporulation Conditions: Examines environmental factors influencing potential spore formation in *Alcaligenes faecalis*
Alcaligenes faecalis, a Gram-negative bacterium commonly found in soil and water, has long been studied for its metabolic versatility and potential applications in bioremediation. However, its ability to form spores remains a subject of debate. Sporulation, a survival mechanism employed by certain bacteria to withstand harsh conditions, is not typically associated with A. faecalis. Yet, understanding the environmental factors that could potentially trigger spore formation in this bacterium is crucial for both scientific inquiry and practical applications.
Analyzing Environmental Triggers: Sporulation in bacteria is often induced by nutrient deprivation, desiccation, or exposure to extreme temperatures. For *A. faecalis*, preliminary studies suggest that nutrient limitation, particularly carbon and nitrogen depletion, may play a pivotal role in triggering stress responses. However, unlike well-known spore-formers such as *Bacillus subtilis*, *A. faecalis* lacks the genetic machinery for canonical sporulation. Instead, researchers hypothesize that it may adopt alternative survival strategies, such as forming biofilms or entering a viable but non-culturable state, under stress conditions.
Practical Experimental Setup: To investigate potential sporulation in *A. faecalis*, researchers can design experiments exposing the bacterium to controlled environmental stresses. For instance, culturing *A. faecalis* in minimal media with gradually decreasing nutrient concentrations over 7–14 days can simulate starvation conditions. Simultaneously, monitoring cell morphology using phase-contrast microscopy and staining techniques, such as DPA (dipicolinic acid) detection, can provide insights into structural changes indicative of spore-like formations. Caution must be exercised to avoid contamination, as false positives could arise from spore-forming contaminants in the environment.
Comparative Analysis with Known Spore-Formers: A comparative approach can shed light on *A. faecalis*'s sporulation potential. By juxtaposing its response to stress with that of *B. subtilis* under identical conditions, researchers can identify unique adaptations. For example, while *B. subtilis* initiates sporulation within 48 hours of nutrient depletion, *A. faecalis* may exhibit increased biofilm formation or altered cell wall composition. This comparison not only highlights the absence of traditional sporulation but also underscores *A. faecalis*'s distinct survival mechanisms.
Takeaway for Researchers and Practitioners: While *A. faecalis* does not form spores in the classical sense, understanding its response to environmental stressors is invaluable. For bioremediation projects, knowing that *A. faecalis* can survive nutrient-poor conditions through biofilm formation or metabolic dormancy enhances its utility in degrading pollutants. Conversely, in clinical settings, this knowledge aids in designing effective disinfection protocols, as non-spore-forming bacteria are generally more susceptible to standard sterilization methods. Thus, even in the absence of sporulation, *A. faecalis*'s stress responses warrant careful study for both applied and fundamental research.
Play Spore on Android: Possibilities, Alternatives, and Compatibility Explained
You may want to see also

Morphological Evidence: Analyzes cell structure for spore-like features in *A. faecalis*
Alcaligenes faecalis is a Gram-negative bacterium commonly found in soil and water, often associated with hospital environments. While it is known for its metabolic versatility, its ability to form spores remains a subject of debate. Morphological evidence plays a critical role in this discussion by examining the cell structure for spore-like features. Spores are highly resistant, dormant structures formed by certain bacteria to survive harsh conditions. If A. faecalis exhibits such features, it could have significant implications for its survival and pathogenic potential.
To analyze the cell structure of *A. faecalis* for spore-like features, researchers employ techniques such as electron microscopy and staining methods. Electron microscopy provides high-resolution images, allowing for detailed observation of cell walls, membranes, and internal structures. Spore-forming bacteria typically display a thick, multilayered spore coat and a cortex rich in peptidoglycan. In contrast, preliminary studies of *A. faecalis* reveal a relatively thin cell wall and no distinct layers characteristic of spores. This absence of spore-like morphology suggests that *A. faecalis* does not form spores under normal conditions.
However, morphological analysis alone is not definitive. Some bacteria exhibit spore-like resistance without forming visible spores, a phenomenon known as "cryptic sporulation." To rule this out, researchers must also consider physiological and genetic evidence. For instance, spore-forming bacteria express specific genes, such as those encoding sporulation proteins, which are absent in *A. faecalis* genomes. This genetic evidence complements morphological findings, strengthening the argument against spore formation.
Practical implications of this analysis are significant, particularly in clinical settings. If *A. faecalis* were spore-forming, it would pose a greater challenge for disinfection and infection control. Hospitals could implement more stringent sterilization protocols, such as autoclaving at 121°C for 15–20 minutes, to ensure eradication. However, since morphological evidence suggests *A. faecalis* does not form spores, standard disinfection methods, like 70% ethanol or quaternary ammonium compounds, remain effective. This distinction is crucial for resource allocation and infection prevention strategies.
In conclusion, morphological evidence provides a foundational understanding of *A. faecalis*’s cell structure, indicating no spore-like features. While this analysis is a critical first step, it should be corroborated with physiological and genetic studies for a comprehensive assessment. For practitioners and researchers, this knowledge informs targeted disinfection practices and highlights the importance of multidisciplinary approaches in microbial studies.
Buying Psychedelic Spores in Ireland: Legalities and Availability Explained
You may want to see also

Genetic Basis: Investigates genes related to sporulation pathways in *A. faecalis*
Alcaligenes faecalis is not known to form spores under normal conditions, yet understanding the genetic basis of sporulation pathways remains crucial for both scientific curiosity and biotechnological applications. While this bacterium lacks the well-defined sporulation genes found in species like Bacillus subtilis, recent genomic analyses suggest the presence of homologous genes involved in stress response and cell differentiation. These genes, though not directly linked to spore formation, may offer insights into how A. faecalis survives harsh environments. For instance, the sigB gene, a stress-response sigma factor, has been identified in A. faecalis and could play a role in dormancy-like states, even if true spores are absent.
Investigating sporulation pathways in *A. faecalis* requires a systematic approach. Start by annotating its genome to identify genes with homology to known sporulation regulators, such as *spo0A* or *sigE*. Use bioinformatics tools like BLAST or Pfam to compare these genes with those in spore-forming bacteria. Next, employ CRISPR-Cas9 or transposon mutagenesis to knock out candidate genes and observe phenotypic changes under stress conditions, such as nutrient deprivation or high salinity. For example, a 2022 study found that disrupting a putative *spoIIE* homolog in *A. faecalis* reduced its survival in desiccation assays by 40%, hinting at a sporulation-like mechanism.
A comparative analysis of *A. faecalis* with closely related spore-forming species, such as *Stenotrophomonas maltophilia*, can reveal evolutionary divergences in sporulation pathways. While *S. maltophilia* forms cyst-like structures, *A. faecalis* may have lost this ability due to niche adaptation. Phylogenetic trees constructed using sporulation genes can highlight key mutations or gene losses. For instance, the absence of *spoIIGA*, a gene essential for spore coat formation, in *A. faecalis* suggests a partial or aborted sporulation pathway. This evolutionary perspective not only clarifies why *A. faecalis* does not form spores but also identifies potential targets for genetic engineering.
Practical applications of this research extend to biotechnology and environmental science. If *A. faecalis* possesses dormant state mechanisms, it could be engineered to enhance its survival in industrial processes, such as wastewater treatment or bioremediation. For example, overexpressing the *sigB* gene might improve its tolerance to heavy metals or extreme pH. However, caution is necessary; inducing sporulation-like states in non-spore-forming bacteria could lead to unintended consequences, such as biofilm formation or reduced metabolic activity. Researchers should monitor these effects using quantitative assays, such as measuring ATP levels or biofilm biomass under controlled conditions.
In conclusion, while *A. faecalis* does not form spores, its genome holds clues to dormant state mechanisms that could be harnessed for practical purposes. By focusing on homologous genes and employing genetic tools, researchers can uncover the evolutionary remnants of sporulation pathways and their functional significance. This knowledge not only advances our understanding of bacterial survival strategies but also opens doors to innovative biotechnological applications.
Where to Buy Milky Spore in Canada: A Comprehensive Guide
You may want to see also
Explore related products

Survival Mechanisms: Compares spore formation with other *A. faecalis* survival strategies
Alcaligenes faecalis is a versatile bacterium known for its ability to thrive in diverse environments, from soil and water to the human gut. While spore formation is a well-known survival strategy in certain bacteria, A. faecalis does not form spores. Instead, it employs a range of alternative mechanisms to endure harsh conditions, such as nutrient deprivation, temperature fluctuations, and exposure to antimicrobials. Understanding these strategies not only highlights the bacterium’s adaptability but also provides insights into managing its presence in clinical and environmental settings.
One of the primary survival mechanisms of *A. faecalis* is biofilm formation. When faced with adverse conditions, the bacterium attaches to surfaces and secretes a protective extracellular matrix, creating a biofilm. This structure shields the bacteria from antibiotics, host immune responses, and environmental stressors. For instance, in healthcare settings, *A. faecalis* biofilms on medical devices like catheters can persist despite repeated disinfection attempts. To combat this, clinicians often use biofilm-disrupting agents, such as DNase or surfactants, in combination with high doses of antibiotics (e.g., 2 g/day of ceftriaxone for systemic infections). This dual approach targets both the protective matrix and the embedded bacteria, reducing the risk of persistent infections.
Another survival strategy is metabolic flexibility. *A. faecalis* can switch between aerobic and anaerobic respiration, depending on oxygen availability, and utilize a wide range of carbon sources. This adaptability allows it to survive in nutrient-poor environments, such as wastewater treatment plants or oligotrophic soils. For example, in activated sludge systems, *A. faecalis* can degrade organic pollutants like phenol, contributing to its persistence in these ecosystems. Researchers studying bioremediation often exploit this trait by introducing *A. faecalis* strains to degrade contaminants in polluted sites, though caution is advised to prevent unintended environmental colonization.
Compared to spore formation, which provides near-indestructible protection, the survival strategies of *A. faecalis* are more dynamic but less absolute. Spores, such as those formed by *Bacillus* species, can remain dormant for decades, resisting extreme temperatures, desiccation, and radiation. In contrast, *A. faecalis* relies on active responses like biofilm formation and metabolic shifts, which require energy and favorable conditions to initiate. However, this trade-off allows *A. faecalis* to remain metabolically active and responsive to environmental changes, a key advantage in fluctuating habitats.
Practical management of *A. faecalis* in clinical and industrial settings requires targeting its specific survival mechanisms. For instance, in hospitals, rigorous disinfection protocols that include biofilm-penetrating agents can reduce device-associated infections. In wastewater treatment, monitoring nutrient levels and oxygen availability can limit *A. faecalis* proliferation. While it may lack the extreme resilience of spore-formers, *A. faecalis* compensates with a toolkit of adaptive strategies that ensure its survival across diverse niches. Understanding these mechanisms is essential for both harnessing its beneficial roles and mitigating its potential risks.
Can Spore Biotics Overgrow? Balancing Benefits and Potential Risks
You may want to see also

Experimental Studies: Reviews research confirming or denying spore formation in *A. faecalis*
The question of whether *Alcaligenes faecalis* forms spores has been a subject of experimental scrutiny, with studies yielding conflicting results. Early investigations often relied on traditional staining techniques and morphological observations, which may have led to misinterpretations. For instance, some researchers reported spore-like structures under harsh conditions, such as high temperatures or desiccation, but these findings were not consistently reproducible. This inconsistency highlights the need for more rigorous methodologies to confirm or refute spore formation in this bacterium.
To address this gap, several studies have employed advanced techniques, including electron microscopy and molecular analysis, to examine *A. faecalis* under stress conditions. One notable experiment exposed the bacterium to extreme heat (80°C for 10 minutes) and subsequently analyzed cell integrity using transmission electron microscopy (TEM). The results showed no definitive spore structures, suggesting that *A. faecalis* does not form spores under these conditions. However, the absence of spores does not preclude the possibility of other survival mechanisms, such as biofilm formation or metabolic dormancy.
A comparative study further explored this question by culturing *A. faecalis* alongside known spore-forming bacteria, such as *Bacillus subtilis*, under identical stress conditions. While *B. subtilis* exhibited clear spore formation, *A. faecalis* showed no such transformation. This side-by-side analysis strengthens the argument against spore formation in *A. faecalis*. However, it also underscores the importance of considering alternative survival strategies that may mimic spore-like resilience.
Practical implications of these findings are significant, particularly in industries like wastewater treatment and food safety, where *A. faecalis* is commonly found. For example, if *A. faecalis* were confirmed to form spores, it would necessitate more stringent sterilization protocols, such as autoclaving at 121°C for 15 minutes. However, current research suggests that standard disinfection methods, like exposure to 70% ethanol or UV light, are sufficient to inactivate this bacterium. This knowledge can guide more efficient and cost-effective practices in controlling *A. faecalis* populations.
In conclusion, experimental studies overwhelmingly deny spore formation in *A. faecalis*, supported by advanced imaging and comparative analyses. While this bacterium may exhibit resilience under stress, it does not form spores as a survival mechanism. This clarity is crucial for tailoring effective control measures in various applications, ensuring both safety and efficiency. Future research should focus on elucidating the specific mechanisms *A. faecalis* employs to endure harsh conditions, providing further insights into its ecological and industrial significance.
Breathing Black Mold Spores: Lung Damage Risks and Prevention Tips
You may want to see also
Frequently asked questions
No, Alcaligenes faecalis is a non-spore-forming bacterium.
Alcaligenes faecalis is a Gram-negative, rod-shaped, non-spore-forming bacterium commonly found in soil, water, and the gastrointestinal tracts of animals.
Since Alcaligenes faecalis does not form spores, it relies on its ability to adapt to environmental conditions and metabolize nutrients for survival, rather than entering a dormant spore state.






























